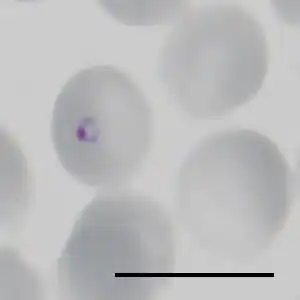

Plasmodium falciparum
| Plasmodium falciparum | ||||||||||||
|---|---|---|---|---|---|---|---|---|---|---|---|---|
| ||||||||||||
| Ringstadium van Plasmodium falciparum in een geïnfecteerde erytrocyt. Het zwarte streepje is 10 μm lang. | ||||||||||||
| Taxonomische indeling | ||||||||||||
| ||||||||||||
| Soort | ||||||||||||
| Plasmodium falciparum Welch, 1897 | ||||||||||||
| Afbeeldingen op | ||||||||||||
| Plasmodium falciparum op | ||||||||||||
| ||||||||||||
Plasmodium falciparum is een eencellige, die de verwekker is van malaria tropica bij mensen. Deze vorm van malaria is potentieel dodelijk en bovendien de gevaarlijkste, omdat er bij deze parasiet de meeste complicaties optreden ten opzichte van malaria verwekt door andere Plasmodium-soorten. De parasiet wordt overgebracht door Anopheles.
Over het algemeen verloopt een infectie met P. falciparum mild, maar is berucht om de plotseling optredende verslechtering, die tot de dood kan leiden.
De incubatietijd bedraagt zeven tot veertien dagen, maar kan langer (tot zes weken) zijn als het immuunsysteem is aangedaan of profylactische malariamiddelen niet goed worden ingenomen.
Zie de categorie Plasmodium falciparum van Wikimedia Commons voor mediabestanden over dit onderwerp.